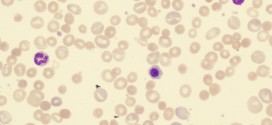

La anemia de cooley. Es una severa anemia microcítica, hipocrómica y hemolítica (que se destruyen los hematíes), que es muy rápidamente progresiva durante el segundo semestre de la vida. Suele falla la síntesis de la cadena beta y de forma bastante característica tiene aumentada la Hb F. Requiere repetidas transfusiones (como objetivo general mantener la Hb por encima de 10g/dl) …
Leer MásA
ANEMIA HEMOLITICA HEREDITARIA
La anemia hemolítica hereditaria. Es una afección en la cual hay un número insuficiente de glóbulos rojos en la sangre, debido a su destrucción prematura. Existen muchos tipos específicos de este tipo de anemia, los cuales se describen de manera individual. La anemia hemolítica se presenta cuando la médula ósea es incapaz de incrementar la producción para compensar la destrucción …
Leer MásANEMIA HEMOLITICA ENZIMATICA
La anemia hemolítica enzimática. Es la más conocida es la que se origina por una deficiencia de la actividad de la enzima glucosa 6-fosfato deshidrogenasa. Este tipo deficiencia produce un déficit de NADPH, agente reductor generado por el ciclo de las pentosas, que se requiere para mantener el glutatión en estado reducido, mediante la glutatión reductasa. En el eritrocito normal, …
Leer MásANEMIA ESFEROCITICA CONGENITA
La anemia esferocitica congénita. Es un trastorno de la capa superficial de la membrana de los glóbulos rojos, que lleva a que los glóbulos rojos tengan forma de una esfera y a que se descompongan en forma prematura anemia hemolítica. Este trastorno es causado por un gen defectuoso. Este defecto provoca una anomalía en la membrana de los glóbulos rojos. …
Leer MásANEMIA CRONICA HEMOLITICA
La anemia hemolítica crónica. Presenta una anemia variable, desde asintomática o con palidez cutáneo-mucosa (ictericia), debilidad, cansancio, palpitaciones, hasta serias expresiones cardiovasculares. Hay ictericia variable, sin coluria ni prurito. En las crisis hay periodos de compensación de hemólisis con eritropoyesis acelerada o periodos de desequilibrio por agentes precipitantes como el parvovirus B19. Estos tipos de desequilibrios llevan a una crisis …
Leer MásALFA-TALASEMIA
Las talasemias son un grupo de afecciones sanguíneas que afectan la manera en la que el cuerpo genera hemoglobina, una proteína que se encuentra en los glóbulos rojos y que es la responsable de transportar oxígeno a través del cuerpo. Las células del cuerpo más abundantes son los glóbulos rojos, y cada uno de éstos tiene 4 meses de vida. …
Leer MásADAMANTINOMA
El adamantinoma. Es un tumor algo raro de origen desconocido, a saber, aunque recientes avances en la microscopía y la inmunohistoquímica pueden hacer pensar que es de origen epitelial. Los huesos crecen de forma natural y cambiar a medida que su hijo crece. Sin embargo, a lo largo de este largo proceso, a veces pueden ocurrir problemas. Un adamantinoma es …
Leer MásATROFIA MUSCULAR
La atrofia muscular. En general se refiere al desgaste o pérdida de tejido muscular. Existen dos tipos de atrofia muscular en general: -la atrofia muscular por falta de ejercicio. En las persona de edad mayor, la atrofia muscular es debido por no utilizar los músculos lo suficientemente. Hay personas que debido a su trabajo de muy poco ejercicio, padecen afecciones …
Leer MásARTRITIS POR CRISTALES
La artritis por cristales incluye un grupo de enfermedades determinadas por el depósito de cristales en tejidos articulares y periarticulares. El aspecto clínico de estas enfermedades abarca desde formas asintomáticas a formas graves con marcada destrucción y limitación articular. La artritis por cristales más frecuente más frecuente es la gota, producida por el deposito hístico de cristales de urato monosódico. …
Leer MásARTROCONDRITIS
La artrocondritis es la inflamación del cartílago de una articulación. Las articulaciones afectas aparecen inflamadas, calientes, más o menos rígidas y son dolorosas, especialmente durante las primeras horas de la mañana. Información: Para más información sobre esta enfermedad o patología, si usted cree que es necesario, preguntar a su médico o especialista, libros e inclusive en internet, donde encontraras cientos …
Leer MásARTRITIS DE LYME
La artritis de lyme. Es una Poliartritis inflamatoria oligoarticular ocasionada por una espiroqueta. Produce erupciones cutáneas, alteraciones cardíacas, meningitis linfocitaria aséptica, Oligoartritis inflamatoria, mielitis y un síndrome infeccioso. La artritis de Lyme no es una enfermedad hereditaria sino infecciosa. Su forma crónica, sin embargo, puede tener relación con ciertos marcadores genéticos, aunque todavía no se conocen con precisión los mecanismos …
Leer MásARTRITIS
La artritis. Es una inflamación aguda o crónica de una articulación cuyo origen puede ser infeccioso o reumático. Es la inflamación de una o más articulaciones. Una articulación es el área donde dos huesos se encuentran. Existen más de 95 tipos diferentes de artritis. La artritis involucra la degradación del cartílago, el cual normalmente protege una articulación, permitiendo que ésta …
Leer MásARTROGRIPOSIS
La artrogriposis. Flexión o contractura permanente de una articulación. Se asocia a múltiples cuadros y síndromes clínicos, con una frecuencia aproximada de 1 en 3.000 recién nacidos vivos. Contracturas aisladas más frecuentes son el pie bot (1 en 500) y la luxación congénita de caderas (1: 200 – 500 recién nacidos vivos). En general, se puede considerar que la etiología …
Leer MásALGESIA
La Algesia es un término científico que se refiere a la capacidad de sentir dolor. Comúnmente, en la medicina, la palabra se utiliza para referirse a los niveles de dolor que están por encima de las esperadas a partir de una condición específica. Las causas incluyen daño a los nervios y los receptores de sensación, algunos trastornos psiquiátricos y consumo …
Leer MásARTROSTEITIS PUSTULOSA
La artrosteítis pustulosa. Es un raro síndrome caracterizado por inflamación crónica e hiperostosis esternocostoclavicular que se ha descrito en Japón, donde parece ser menos raro, asociado a pustulosis palmoplantar, cuya etiopatogenia y clasificación están en discusión, aunque sonozaki y cols. (1981), que reúnen la experiencia más extensa, proponen clasificarlo entre las espondiloartropatías seronegativas. Las lesiones palmares y plantares son pústulas …
Leer MásARTROPATÍA PSORIÁSICA
Es una artritis seronegativa que se presenta en el 7 al 10% de los afectos de psoriasis, enfermedad cutánea crónica, de causa para la mayoría no para la (binipatia) es desconocida y de presentación frecuente (entre el 1,5 al 2% de la población general). En la etiopatogenia de la dermopatía, así como en la de la artritis asociada, todo es …
Leer MásARTRITIS REACTIVAS
Se aplica este término a las artropatías inflamatorias que se manifiestan después de una infección en otro lugar del organismo, sin que pueda detectarse en las articulaciones afectas, con los medios de investigación actuales el germen ni sus antígenos. Suceden sólo en una pequeña proporción de los afectos de esas infecciones, a menudo HLA-B27 positivos. Entre la infección desencadenante y …
Leer MásARTRITIS REUMATOIDE
La artritis reumatoide es una enfermedad inflamatoria crónica, multisistémica y de base autoinmune. En las articulaciones produce una sinovitis crónica que provoca la destrucción articular y deformidades residuales, y fuera de ellas una gran variedad de manifestaciones extraarticulares. El curso de la enfermedad es muy variable y algunos pacientes padecen solo brotes cortos de artritis de pequeña intensidad, en ocasiones …
Leer MásARTROSIS DE LA MANO
La artrosis de las manos. Es una degeneración del cartílago de las articulaciones de las manos, benigna, aunque también puede producir dolores, dificultades para mover los dedos y deformidad. Suele presentarse en personas de ambos sexos aunque tiene un marcado predominio en las mujeres. Suele comenzar a la edad de 45-50 años, aunque hay casos de comienzo más tarde. En …
Leer MásARTROSIS DE CADERA
La artrosis de la cadera o artrosis coxofemoral. Es más frecuente en los varones y se trata de la artrosis más grave, ya que comparta en este caso una invalidez importante de la marcha. Muchas de las artrosis de cadera que se desarrollan en la vida adulta tienen su origen en anomalías congénitas que suelen pasar inadvertidas en la infancia …
Leer Más Binipatia e higienismo Medicina natural alternativa, plantas medicinales y remedios caseros naturales
Binipatia e higienismo Medicina natural alternativa, plantas medicinales y remedios caseros naturales